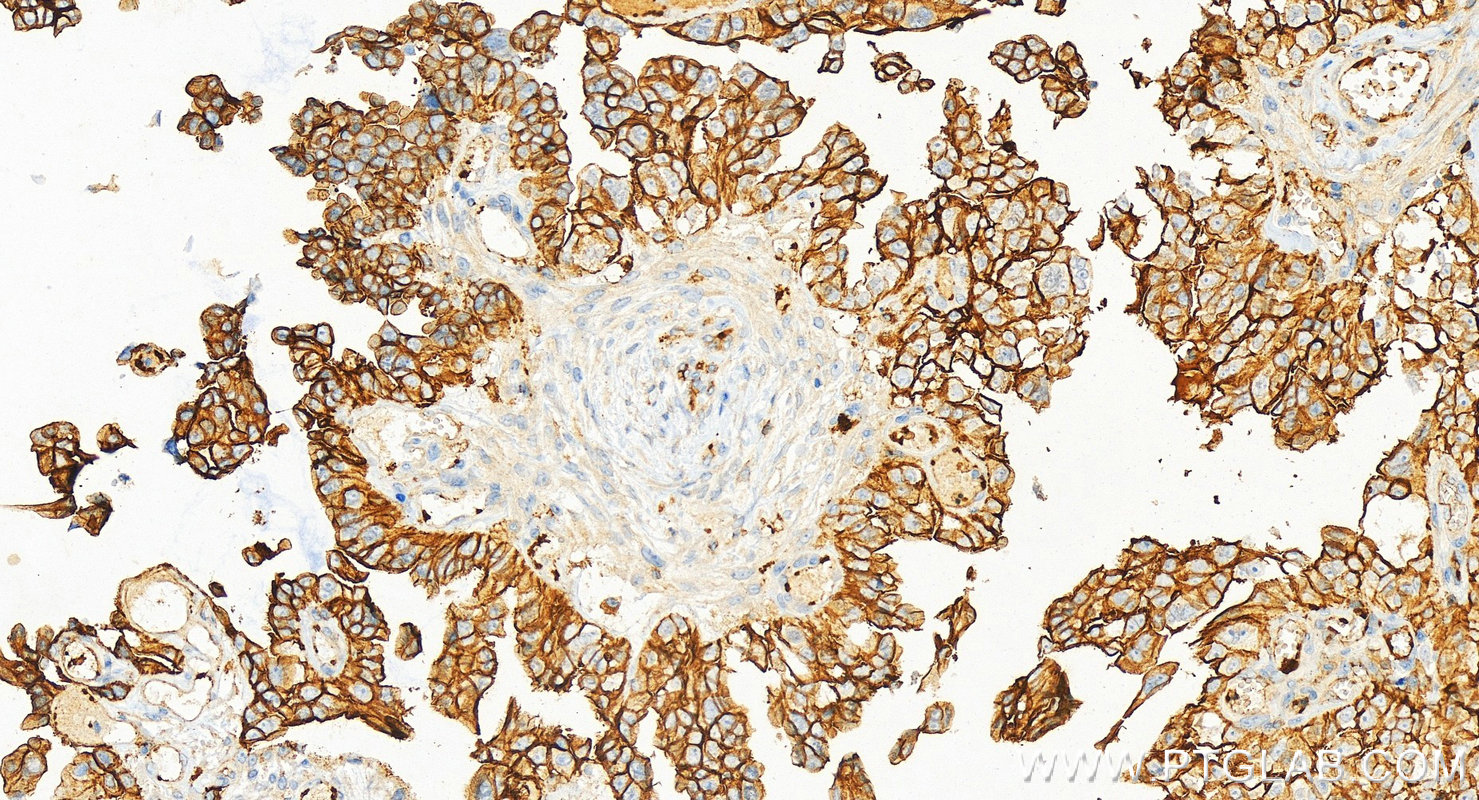

验证数据展示
经过测试的应用
| Positive WB detected in | HCT 116 cells, HeLa cells, L02 cells |
| Positive IHC detected in | human lung cancer tissue, human breast cancer tissue, human endometrial cancer tissue, human ovary cancer tissue Note: suggested antigen retrieval with TE buffer pH 9.0; (*) Alternatively, antigen retrieval may be performed with citrate buffer pH 6.0 |
| Positive IF/ICC detected in | MCF-7 cells |
推荐稀释比
| 应用 | 推荐稀释比 |
|---|---|
| Western Blot (WB) | WB : 1:2000-1:12000 |
| Immunohistochemistry (IHC) | IHC : 1:1000-1:4000 |
| Immunofluorescence (IF)/ICC | IF/ICC : 1:50-1:500 |
| It is recommended that this reagent should be titrated in each testing system to obtain optimal results. | |
| Sample-dependent, Check data in validation data gallery. | |
产品信息
20597-1-AP targets CD9 in WB, IHC, IF/ICC, IP, ELISA applications and shows reactivity with human samples.
| 经测试应用 | WB, IHC, IF/ICC, ELISA Application Description |
| 文献引用应用 | WB, IHC, IF, IP |
| 经测试反应性 | human |
| 文献引用反应性 | human, mouse, rat, pig, rabbit, monkey, chicken, zebrafish, goat, bat |
| 免疫原 |
CatNo: Ag14546 Product name: Recombinant human CD9 protein Source: e coli.-derived, PGEX-4T Tag: GST Domain: 100-208 aa of BC011988 Sequence: FAIEIAAAIWGYSHKDEVIKEVQEFYKDTYNKLKTKDEPQRETLKAIHYALNCCGLAGGVEQFISDICPKKDVLETFTVKSCPDAIKEVFDNKFHIIGAVGIGIAVVMI 种属同源性预测 |
| 宿主/亚型 | Rabbit / IgG |
| 抗体类别 | Polyclonal |
| 产品类型 | Antibody |
| 全称 | CD9 molecule |
| 别名 | 5H9, 5H9 antigen, BA2, BTCC 1, CD9 antigen |
| 计算分子量 | 228 aa, 25 kDa |
| 观测分子量 | 23-30 kDa |
| GenBank蛋白编号 | BC011988 |
| 基因名称 | CD9 |
| Gene ID (NCBI) | 928 |
| RRID | AB_2878706 |
| 偶联类型 | Unconjugated |
| 形式 | Liquid |
| 纯化方式 | Antigen affinity purification |
| UNIPROT ID | P21926 |
| 储存缓冲液 | PBS with 0.02% sodium azide and 50% glycerol, pH 7.3. |
| 储存条件 | Store at -20°C. Stable for one year after shipment. Aliquoting is unnecessary for -20oC storage. |
背景介绍
The cell-surface molecule CD9, a member of the transmembrane-4 superfamily, interacts with the integrin family and other membrane proteins, and is postulated to participate in cell migration and adhesion. Expression of CD9 enhances membrane fusion between muscle cells and promotes viral infection in some cells (PMID:10459022). It is often used as a mesenchymal stem cell marker (PMID:18005405). The CD9 antigen appears to be a 227-amino acid molecule with four hydrophobic domains and one N-glycosylation site (PMID: 1840589). This antibody detects bands of 23-30 kDa, it may be due to the difference of glycosylations (PMID: 8701996).
实验方案
| Product Specific Protocols | |
|---|---|
| IF protocol for CD9 antibody 20597-1-AP | Download protocol |
| IHC protocol for CD9 antibody 20597-1-AP | Download protocol |
| WB protocol for CD9 antibody 20597-1-AP | Download protocol |
| Standard Protocols | |
|---|---|
| Click here to view our Standard Protocols |
发表文章
| Species | Application | Title |
|---|---|---|
Signal Transduct Target Ther Circulating tumor cells shielded with extracellular vesicle-derived CD45 evade T cell attack to enable metastasis | ||
Gastroenterology PTEN deficiency facilitates exosome secretion and metastasis in cholangiocarcinoma by impairing TFEB-mediated lysosome biogenesis | ||
Bioact Mater Profibrogenic macrophage-targeted delivery of mitochondrial protector via exosome formula for alleviating pulmonary fibrosis | ||
Nat Commun Injectable ECM-mimetic dynamic hydrogels abolish ferroptosis-induced post-discectomy herniation through delivering nucleus pulposus progenitor cell-derived exosomes | ||
J Extracell Vesicles Quantification of urinary podocyte-derived migrasomes for the diagnosis of kidney disease |